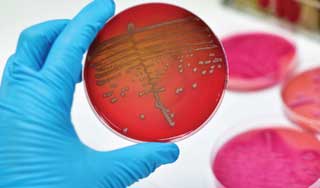

Описание заболевания
Сепсис крови представляет собой заболевание, которое возникает в результате вторичного инфицирования организма, когда патогенные микроорганизмы проникают в кровоток из первичного очага инфекции. Многие пациенты обращаются за медицинской помощью по поводу других заболеваний, и лишь спустя некоторое время у них выявляется наличие заражения.
Сепсис является серьезным патологическим состоянием, способным нарушить функционирование всех систем и органов, что представляет опасность для здоровья и жизни пациента. При первых признаках заболевания необходимо срочно госпитализировать пациента.
Сепсис — это серьезное состояние, возникающее в результате реакции организма на инфекцию. Врачи подчеркивают, что сепсис может развиваться из-за различных инфекций, включая пневмонию, инфекции мочевыводящих путей и абсцессы. Основные проявления сепсиса включают высокую температуру, учащенное сердцебиение, затрудненное дыхание и спутанность сознания. Важно отметить, что симптомы могут варьироваться в зависимости от возраста и общего состояния пациента. Врачи настоятельно рекомендуют не игнорировать эти признаки, так как сепсис требует немедленного медицинского вмешательства. При отсутствии своевременной помощи состояние может быстро ухудшиться, что приводит к серьезным осложнениям и даже летальному исходу. Поэтому ранняя диагностика и лечение сепсиса являются ключевыми факторами для успешного восстановления пациента.

Виды и формы
Инфекционные агенты могут попадать в человеческий организм различными путями. В зависимости от типа инфекции формируется первичный воспалительный очаг. Классификация этого патологического состояния в первую очередь зависит от места, где локализован начальный источник инфекции.
Сепсис может быть:
- стрептококковым;
- пневмококковым;
- колибациллярным;
- анаэробным;
- менингококковым;
- стафилококковым;
- синегнойным.
В зависимости от локализации возбудителя, заболевание делится на следующие виды:
- Послеоперационный. Его развитие связано с нарушением асептики во время хирургического вмешательства.
- Уросепсис. Характеризуется активным размножением возбудителя из очагов, находящихся в мочеполовой системе. Особенностью этого типа является наличие гнойных и воспалительных процессов в мочевом пузыре.
- Хирургический сепсис. Возникает из-за гнойных процессов и осложнений, связанных с внутренними и внешними гнойничковыми образованиями.
- Риногенный. Диагностируется крайне редко. Для него характерно наличие первичного очага в околоносовых пазухах и носовой полости.
- Акушерско-гинекологический. Формируется в результате осложнений при родах или оперативных вмешательствах на половых органах женщин. Заболевание протекает тяжело и может возникать после выкидыша или аборта, выполненного недостаточно квалифицированным специалистом.
- Отогенный. Один из самых опасных видов, так как его причиной часто становится осложнение гнойного отита. Это может привести к инфекционному распространению в головной мозг, что вызывает развитие менингита.
Сепсис также классифицируется по стадии течения:
- острый – заболевание развивается медленно;
- молниеносный – начинается стремительно, протекает тяжело и имеет неблагоприятный прогноз;
- подострый – может длиться до 90 дней;
- хронический сепсис – развивается в течение около года.
Кроме того, выделяется рецидивирующая форма, при которой обострения чередуются с полным выздоровлением.
| Симптом | Описание | Возможные причины (связанные с сепсисом) |
|---|---|---|
| Высокая температура (лихорадка) | Температура тела выше 38°C. | Инфекция, распространяющаяся по организму. |
| Озноб | Сильное чувство холода, дрожь. | Реакция иммунной системы на инфекцию. |
| Учащенное сердцебиение (тахикардия) | Сердце бьется быстрее, чем обычно. | Организм пытается компенсировать снижение кровяного давления. |
| Учащенное дыхание (тахипноэ) | Дыхание становится более частым и поверхностным. | Организм пытается получить больше кислорода. |
| Снижение артериального давления (гипотензия) | Кровяное давление падает ниже нормы. | Септический шок – опасное осложнение сепсиса. |
| Слабость и утомляемость | Чувство общей слабости и истощения. | Организм борется с инфекцией. |
| Головная боль | Боль в голове различной интенсивности. | Воспаление, вызванное инфекцией. |
| Боль в мышцах и суставах | Боль и скованность в мышцах и суставах. | Воспалительный процесс. |
| Тошнота и рвота | Чувство тошноты и рвота. | Реакция организма на инфекцию. |
| Потеря аппетита | Отсутствие желания есть. | Общее недомогание. |
| Спутанность сознания | Дезориентация, спутанность мышления. | Недостаток кислорода в мозге. |
| Сыпь | Появление сыпи на коже. | Септический шок, аллергическая реакция. |
| Холодные, липкие конечности | Конечности становятся холодными и влажными на ощупь. | Снижение кровотока к периферии. |
| Изменение цвета кожи (цианоз) | Посинение кожи, особенно на пальцах и губах. | Недостаток кислорода в крови. |
Причины сепсиса
Основными факторами, способствующими развитию сепсиса, являются патогенные микроорганизмы и бактерии. К ним можно отнести:
- стафилококки;
- клебсиеллы;
- микобактерии, вызывающие туберкулез;
- кишечные палочки;
- пневмококки;
- синегнойные палочки;
- менингококки.
Инфекция может распространяться по организму в следующих случаях:
- при нарушениях иммунной реакции;
- из-за быстрого распространения штаммов, устойчивых к антибиотикам;
- в результате неправильно выбранной хирургической тактики и неадекватного выполнения операций;
- при наличии сопутствующих заболеваний.
Причины развития данной патологии могут включать:
- рахит;
- диабет;
- ослабленный иммунитет;
- онкологические заболевания;
- тяжелые травмы и ожоги;
- длительное применение иммуносупрессоров.
Важно отметить, что даже самый интенсивный воспалительный процесс не всегда приводит к сепсису. Более того, здоровый человек способен самостоятельно справиться с инфекцией без необходимости в медикаментозном лечении, не вызывая при этом осложнений.
Сепсис — это серьезное состояние, возникающее в результате реакции организма на инфекцию. Люди часто описывают его как «инфекцию, которая вышла из-под контроля». Симптомы могут варьироваться, но чаще всего это высокая температура, озноб, учащенное сердцебиение и затрудненное дыхание. Многие отмечают, что сепсис может развиваться стремительно, и важно не игнорировать первые признаки. Врачи подчеркивают, что ранняя диагностика и лечение критически важны для успешного исхода. Некоторые пациенты делятся своими историями о том, как быстро ухудшалось состояние, и как важно было обратиться за медицинской помощью. Сепсис может затронуть любого, но особенно уязвимы пожилые люди и те, у кого уже есть хронические заболевания.

Симптомы и проявления
Развитие сепсиса проявляется рядом характерных признаков:
- температура тела поднимается выше 38 градусов или опускается ниже 36;
- учащенное сердцебиение;
- увеличение частоты дыхательных движений;
- уровень лейкоцитов в крови может достигать четырех или превышать 12.
Ключевые симптомы данной патологии:
- гипотермия или высокая температура;
- частое сердцебиение;
- учащенное дыхание;
- спутанность сознания или кома;
- отклонения в количестве лейкоцитов в крови;
- пониженное или повышенное артериальное давление на фоне септического шока;
- бледность кожи;
- высыпания на коже и слизистых оболочках.
Признаки заболевания у взрослых часто возникают после медицинских процедур, таких как операции, установка катетеров или инъекции.
Прогрессирование заболевания может сопровождаться:
- быстрой утомляемостью;
- тошнотой и рвотой;
- снижением аппетита;
- головокружением;
- головными болями;
- образованием уплотнений или гнойников;
- нарушениями стула;
- резкой и необъяснимой потерей веса;
- постоянным повышением температуры.
Важно также обратить внимание на внешний вид пациента. Обычно лицо выглядит осунувшимся, кожа может иметь желтоватый оттенок. На языке наблюдается сухой налет, а тело может быть покрыто петехиальной сыпью.
Сепсис у детей, включая новорожденных
В период новорожденности данное заболевание считается наиболее угрожающим. Различные микроорганизмы и патогенные бактерии выступают в роли его провокаторов. Чаще всего основными виновниками являются гемолитический стрептококк и стафилококк.
Реже к развитию болезни могут привести кишечная и синегнойная палочки, а также клебсиелла.
Инфекционный процесс проникает в организм младенца через:
- мочеполовую систему и желудочно-кишечный тракт;
- пупочную рану;
- поврежденные участки кожи и слизистых оболочек.
Предрасполагающими факторами для новорожденных могут быть и некоторые заболевания:
- пневмония;
- кишечные инфекции;
- отит;
- фарингит;
- бронхит.
Кроме того, развитие сепсиса у новорожденных может способствовать:
- травмы, полученные во время родов;
- длительная искусственная вентиляция легких;
- венозная катетеризация;
- гипоксия;
- тяжелая недоношенность;
- наследственные заболевания;
- конъюнктивит;
- нарушения иммунной системы;
- питание через зонд;
- сложные хирургические операции, проведенные в первые дни жизни.
К основным симптомам заболевания у детей относятся:
- покраснение в области пупка;
- низкая активность;
- замедленный набор веса;
- беспокойство;
- срыгивание;
- высокая температура;
- гнойные, кровянистые или прозрачные выделения из пупка.
В процессе болезни могут развиваться серьезные состояния и осложнения:
- пневмония;
- абсцесс;
- гнойный артрит;
- тахикардия.
При диагностировании молниеносной формы сепсиса у ребенка может возникнуть септический шок, что в большинстве случаев приводит к летальному исходу.

Диагностика
Способы диагностики заболевания зависят от места расположения и типа поражения. Наиболее распространенными методами являются:
- ультразвуковое исследование печени, почек и других внутренних органов;
- компьютерная томография;
- электрокардиограмма (ЭКГ);
- рентгенографическое обследование;
- магнитно-резонансная томография;
- анализ крови в лабораторных условиях.
Выявить инфекцию в кровяной жидкости порой бывает непросто. Существует вероятность, что первичный очаг не будет обнаружен. Картина прогрессирования патологического процесса может быть размыта.
Терапевтические методы
В процессе прогрессирования септического состояния происходит сбой в функционировании всех органов и систем, что создает значительную угрозу для жизни пациента. По этой причине при выявлении данного заболевания пациента обязательно госпитализируют. Чаще всего лечение осуществляется в отделении интенсивной терапии или хирургическом отделении.
Медикаментозное лечение
Клинические рекомендации включают в себя назначение:
- антибиотиков (группа левомицетинов, пенициллины, аминогликозиды, цефалоспорины);
- иммуностимуляторов (Тимоген, Тималин, Рибомулин, Биостим и другие);
- внутривенного введения растворов, что способствует увеличению объема крови, восстановлению кровотока, нормализации свойств плазмы, а также выведению токсинов и воспалительных веществ.
Также могут применяться растворы на основе солей и белков, а также жидкости, которые заменяют кровь.
Кроме того, врач может рекомендовать следующие препараты:
- витаминные комплексы;
- обезболивающие средства;
- препараты для повышения артериального давления;
- средства, улучшающие кровообращение.
Каждому пациенту терапевтическая схема подбирается индивидуально, с учетом особенностей течения заболевания, состояния организма и общего самочувствия.
Оперативное вмешательство
Пока инфекционный очаг не будет ликвидирован, медикаментозное лечение не даст ожидаемого эффекта. Поэтому проводится операция, состоящая из нескольких этапов. Необходимо:
- вскрыть гнойное образование;
- удалить инфекционную жидкость из полости;
- иссечь все пораженные ткани;
- обработать раневую поверхность антисептиком.
В процессе лечения сепсиса пациенту следует соблюдать сбалансированное питание, включающее легко усваиваемые продукты. В рационе обязательно должны быть продукты животного происхождения, а также сахар и углеводы.
Профилактические мероприятия
Для профилактики заболевания эксперты советуют придерживаться ряда рекомендаций:
- тщательно выполнять гигиенические процедуры;
- своевременно устранять источники инфекции и гнойные образования;
- осуществлять антисептическую обработку при повреждении кожи;
- не использовать антибиотики без назначения медицинского специалиста;
- проходить необходимые вакцинации.
Соблюдение этих мер поможет избежать возникновения сепсиса.
Осложнения и прогноз
К числу основных негативных последствий можно отнести:
- кровотечения;
- острую печеночную и почечную недостаточность;
- тромбоэмболию;
- септический шок;
- воспаление легких;
- эндокардит;
- пиелонефрит.
Важно подчеркнуть, что независимо от характера протекания заболевания прогноз не всегда бывает благоприятным. Однако при своевременном начале терапии вероятность полного выздоровления существенно увеличивается.
Вопрос-ответ
Каковы основные симптомы сепсиса?
Симптомы сепсиса могут варьироваться, но наиболее распространенные включают высокую температуру или озноб, учащенное сердцебиение, учащенное дыхание, спутанность сознания, а также резкую слабость или усталость. Важно отметить, что симптомы могут развиваться быстро и требуют немедленного медицинского вмешательства.
Как диагностируется сепсис?
Диагностика сепсиса обычно включает в себя клинический осмотр, анализы крови для определения наличия инфекции и оценки функции органов, а также дополнительные тесты, такие как рентгенография или УЗИ, для выявления источника инфекции. Врач может использовать специальные шкалы, такие как SOFA или qSOFA, для оценки состояния пациента.
Каковы основные методы лечения сепсиса?
Лечение сепсиса включает в себя немедленное введение антибиотиков для борьбы с инфекцией, а также поддерживающую терапию, такую как внутривенные жидкости и, при необходимости, лекарства для поддержания артериального давления. В тяжелых случаях может потребоваться госпитализация в отделение интенсивной терапии для более тщательного наблюдения и лечения.
Советы
СОВЕТ №1
Обратите внимание на симптомы. Сепсис может проявляться различными симптомами, такими как высокая температура, озноб, учащенное сердцебиение, спутанность сознания и одышка. Если вы заметили у себя или у близких подобные признаки, не откладывайте визит к врачу.
СОВЕТ №2
Знайте факторы риска. Люди с ослабленной иммунной системой, хроническими заболеваниями или после хирургических вмешательств находятся в группе риска. Если вы относитесь к этой категории, будьте особенно внимательны к своему здоровью и регулярно проходите медицинские осмотры.
СОВЕТ №3
Не игнорируйте инфекции. Даже легкие инфекции, такие как простуда или инфекции мочевых путей, могут привести к сепсису, если их не лечить. Следите за своим состоянием и обращайтесь к врачу при ухудшении самочувствия.
СОВЕТ №4
Обучите своих близких. Расскажите семье и друзьям о признаках и симптомах сепсиса. Чем больше людей будет осведомлено, тем быстрее можно будет получить необходимую медицинскую помощь в случае необходимости.